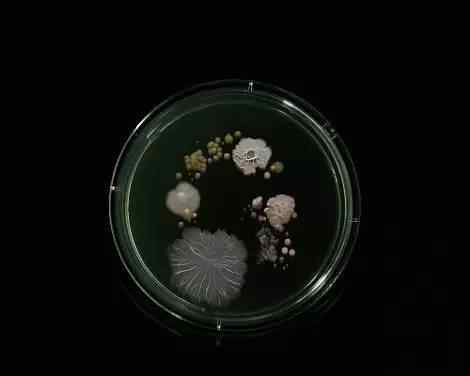

这是从纽约地铁4号线、5号线、6号线、6号线采集的微生物培养结果,其中部分还含有无乳链球菌。

S线地铁上的细菌,包括大肠杆菌、沙门氏菌、金黄色葡萄球菌。这些细菌在培养皿中繁殖,形成地铁线路代码的形状。

地铁l号线的细菌包括大肠杆菌、奇异变形杆菌、藤黄微球菌、枯草芽孢杆菌和粘质沙雷氏菌。

“我对这个项目的成功感到非常兴奋,”沃德说。“我认为这是一个非常有趣的想法,但我不确定我会得到什么结果。”

沃德说:“我从L线开始,后来成为我的最爱。这里的细菌是最多样和丰富多彩的。说实话,我真的很高兴这个项目能成功。”

地铁n、q、r号线细菌沃德发现大量病原体,包括大肠杆菌、沙门氏菌、葡萄球菌。

地铁Z线的细菌,包括普通变形杆菌,通常出现在粪便中。

地铁D线细菌,包括大肠杆菌、金黄色葡萄球菌、霉菌。沃德说:“如果你从正常的角度看地铁,你会看到不同体型、不同肤色的人。当你从微生物的角度去看,你也会发现各种形状、大小、颜色的细菌群落。”
地铁G线微生物包括大肠杆菌、沙门氏菌、藤黄微球菌、枯草芽孢杆菌。沃德说:“这是一个非常小规模的城市表征。”

地铁7号线微生物,包括金黄色葡萄球菌和藤黄微球菌。自2013年以来,科学家和志愿者在纽约地铁中发现了637种已知的细菌、病毒、真菌和动物。
1.《藤黄微球菌 地铁里看不见的细菌:科学与艺术的结合!》援引自互联网,旨在传递更多网络信息知识,仅代表作者本人观点,与本网站无关,侵删请联系页脚下方联系方式。
2.《藤黄微球菌 地铁里看不见的细菌:科学与艺术的结合!》仅供读者参考,本网站未对该内容进行证实,对其原创性、真实性、完整性、及时性不作任何保证。
3.文章转载时请保留本站内容来源地址,https://www.lu-xu.com/fangchan/1022852.html


